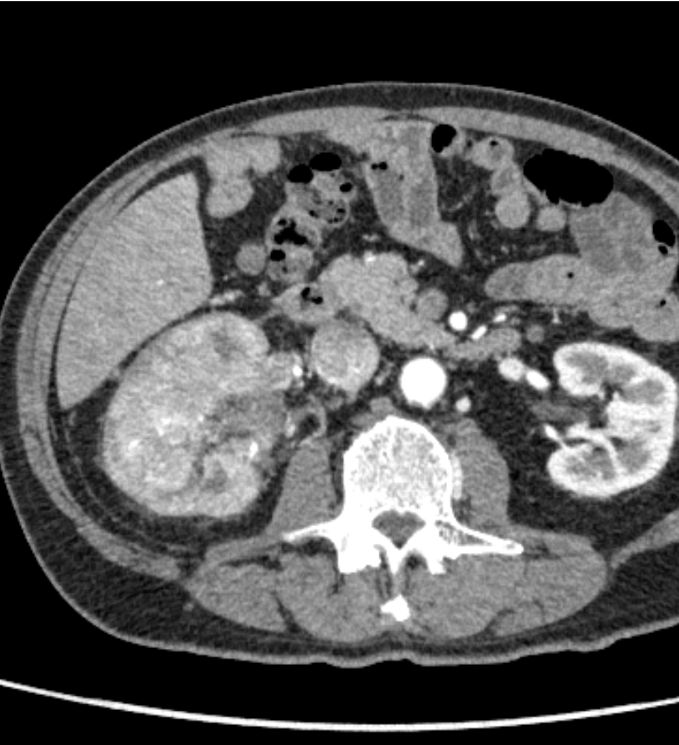
図１．動脈相（横断像）

症例・導⼊事例
※ご紹介する症例は臨床症例の一部を紹介したもので、全ての症例が同様な結果を示すわけではありません。
右腎癌,下大静脈進展,肺動脈腫瘍栓
施設名: 山形大学医学部附属病院
執筆者: 放射線診断科 菅井 康大 先生、鹿戸 将史 先生 / 放射線部 佐藤 俊光 先生
作成年月:2024年9月
※ 効能又は効果、用法及び用量、警告・禁忌を含む注意事項等情報等については、電子添文をご参照ください。
はじめに
症例背景
60歳代、男性、71kg、右腎癌
検査目的
肉眼的血尿で前医受診。右腎癌、IVC浸潤、肺動脈塞栓症、肺転移が疑われた。
使用造影剤
イオプロミド370注シリンジ100mL「BYL」/ 75mL
症例解説
右腎には、実質を置換性に広がる早期濃染とwashoutを示す腫瘍を認め、腎細胞癌と考えられた。腫瘍は腎静脈を経て下大静脈に進展し横隔膜レベルに達していた。また左腎動脈には低造影域を認め、肺動脈腫瘍栓と考えられた。
撮影プロトコル
表は横スクロールでご覧いただけます。
| 使用機器 | CT機種名/メーカー名 | Aquilion PRIME / キヤノンメディカルシステムズ |
| CT検出器の列数/スライス数 | 80 / 80 | |
| ワークステーション名/メーカー名 | Ziostation2 / ザイオソフト |
撮影条件
表は横スクロールでご覧いただけます。
| 撮影時相 | 単純 | 動脈相 | 平衡相 | 遅延相 |
|---|---|---|---|---|
| 管電圧 (kV) | 100 | 100 | 100 | 100 |
| AEC | SD:12 (5mm) | SD:12 (5mm) | SD:12 (5mm) | SD:12 (5mm) |
| ビーム幅 (mm) | 40 | 40 | 40 | 40 |
| 撮影スライス厚 (mm) | 0.5 | 0.5 | 0.5 | 0.5 |
| 焦点サイズ | Small | Small | Small | Small |
| スキャンモード | Helical | Helical | Helical | Helical |
| スキャン速度(sec/rot) | 0.5 | 0.5 | 0.5 | 0.5 |
| ピッチ | 0.813 | 0.813 | 0.813 | 0.813 |
| スキャン範囲 | 上腹部 | 胸部~上腹部 | 上腹部 | 上腹部~足関節 |
| 撮影時間 (sec) | 5.3 | 8.5 | 5.3 | 24 |
| 撮影方向 | 頭→足 | 頭→足 | 頭→足 | 頭→足 |
再構成条件
表は横スクロールでご覧いただけます。
| 単純 | 動脈相 | 平衡相 | 遅延相 | |
|---|---|---|---|---|
| ルーチン:再構成スライス厚/間隔 (mm/mm) | 1.0 / 1.0 | 1.0 / 1.0 | 1.0 / 1.0 | 1.0 / 1.0 |
| ルーチン:再構成関数/逐次近似応用法 | AIDR3D Standard | AIDR3D Standard | AIDR3D Standard | AIDR3D Standard |
| 3D/MPR用:再構成スライス厚/間隔 (mm/mm) | 0.5 / 0.25 | 0.5 / 0.25 | 0.5 / 0.25 | 0.5 / 0.25 |
| 3D/MPR用:再構成関数/逐次近似応用法 | AIDR3D Standard | AIDR3D Standard | AIDR3D Standard | AIDR3D Standard |
造影条件
| 自動注入器機種名/メーカー名 | デュアルショットGX7 / 根本杏林堂 |
|---|---|
| 造影剤名 | イオプロミド370注シリンジ |
表は横スクロールでご覧いただけます。
| 撮影プロトコル | 動脈相 |
|---|---|
| 造影剤:投与量 (mgI/mL) | 391 |
| 造影剤:注入時間 (sec) | 30 |
| 生食:投与量 (mL) | 25 |
| 生食:注入時間 (sec) | 8 |
| スキャンタイミング | BT法(第2腰椎レベル/大動脈/+100HU) |
| ディレイタイム | トリガー後10s |
| 留置針サイズ (G) | 20 |
| 注入圧リミット (kg/cm2) | 13 |
当該疾患の診断における造影CTの役割
腎腫瘍の診断において、ダイナミック造影CTはその組織型の推定に有用である。腎腫瘍の多くの割合を占める通常型(淡明細胞型)腎細胞癌は、早期相で周囲の腎皮質と同程度に濃染し(早期濃染)、後期相では周囲に比してやや低造影を示す(washout)ことが特徴である。さらに、腫瘍増大に伴い、本症例のように腎静脈や下大静脈へ進展が見られやすいのも特徴の一つと言えるだろう。また、本症例では腎動脈に塞栓を疑う低造影域を認めた。多くは血栓塞栓であり、その場合は原因となる下肢静脈血栓の有無を検索する必要がある。しかし、本症例では肺動脈内病変には斑な造影効果を認め、FDG-PET(非提示)では集積像を示した。静脈内進展を伴う腎腫瘍の存在と合わせて肺動脈腫瘍栓と診断した。肺動脈塞栓を認めた場合には、血栓以外の可能性についても一考することが大切である。
CT技術や撮像プロトコル設定について
腎機能が低下していたため、造影剤を30%減量し、低管電圧にて撮影を行った。画像はノイズ成分が増加するため、通常より逐次近似応用再構成法の強度を1段階上げることで画質を担保するよう工夫した。